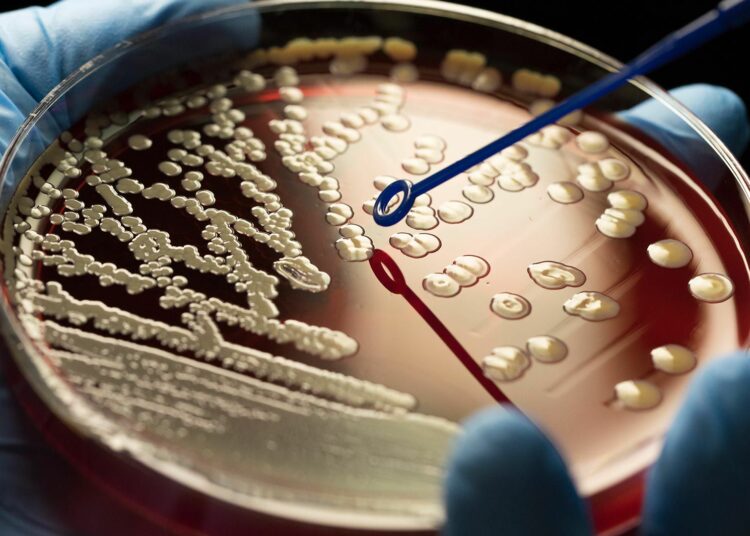
Expertos de Harvard crearon una ‘superbacteria’ inmune a todas las infecciones virales de la naturaleza

Los investigadores de la Escuela de Medicina de Harvard en los Estados Unidos han hecho un progreso significativo en la ingeniería genética y la biología sintética. Han modificado una cepa de E. coli para hacerla inmune a todas las infecciones virales conocidas en la naturaleza, mientras que al mismo tiempo también minimizan las posibilidades de que la bacteria o sus genes modificados escapen a la naturaleza.
El trabajo promete reducir el riesgo de contaminación viral usando bacterias para producir drogas como la insulina y otras sustancias útiles, como los biocombustibles. Actualmente, los virus que infectan cubas de bacterias pueden detener la producción, comprometer la seguridad de los medicamentos y costar millones de dólares.
“Creemos que hemos desarrollado la primera tecnología para diseñar un organismo que no puede ser infectado por ningún virus conocido. No podemos decir que sea completamente resistente a los virus, pero hasta ahora, según extensos experimentos de laboratorio y análisis computacionales, no hemos encontrado un virus que pueda romperlo”, afirmó el primer autor del estudio que fue publicado en Nature, Akos Nyerges.
En ese sentido, el además investigador en genética en el laboratorio de George Church en el Instituto Blavatnik de Harvard explicó: “El trabajo también proporciona la primera medida de seguridad incorporada que evita que el material genético modificado se incorpore a las células naturales”.
Según indicaron los científicos, su documento sugiere un método general para hacer que cualquier organismo sea inmune a los virus y prevenir el flujo de genes hacia y desde los cuerpos modificados genéticamente (OGM). Tales estrategias de biocontención son de creciente interés a medida que los grupos exploran el despliegue seguro de OGM para el cultivo, la reducción de la propagación de enfermedades, la generación de biocombustibles y la eliminación de contaminantes de ambientes abiertos.
El desarrollo se basa en los esfuerzos anteriores de los ingenieros genéticos para lograr una bacteria útil, segura y resistente a los virus. Ya en 2022, un grupo de la Universidad de Cambridge pensó que había creado una cepa de E. coli inmune a los virus. Pero, con el aporte de nuevos investigadores que tomaron muestras de sitios locales plagados con este patógeno, incluidos cobertizos de pollos, nidos de ratas, aguas residuales y el río Muddy en la calle del campus de Harvard, descubrieron virus que aún podrían infectar a las bacterias modificadas. “Descubrir que no eran completamente resistentes a los virus fue un fastidio”, se sinceró Nyerges.
El método que habían aplicado implicaba la reprogramación genética de E. coli para producir todas las proteínas que sustentan la vida a partir de 61 conjuntos de bloques de construcción genéticos, o codones, en lugar de los 64 naturales. La idea era que los virus no podrían secuestrar las células porque no podrían replicarse sin los codones faltantes. Sin embargo, los investigadores descubrieron que eliminar los codones no era suficiente. Algunos virus traían su propio equipo para sortear las piezas faltantes. Entonces, Nyerges y sus colegas desarrollaron una forma de cambiar lo que esos codones le dicen a un organismo que haga, algo que los científicos no habían hecho hasta este punto en las células vivas.
Nuevo tipo de diálogo
La clave estaba en los ARN de transferencia o ARNt. La función de cada ARNt es reconocer un codón específico y agregar el aminoácido correspondiente a una proteína que se está construyendo. Por ejemplo, el codón TCG le dice a su ARNt coincidente que se una al aminoácido serina. En este caso, el equipo de trabajo eliminó TCG junto con el codón hermano TCA, que también requiere serina. Los especialistas también habían eliminado los ARNt correspondientes. En tanto, ahora agregaron nuevos ARNt “tramposos” en su lugar. Cuando estos ARNt ven TCG o TCA, agregan leucina en lugar de serina. “La leucina es física y químicamente diferente de la serina”, explicó Nyerges.
Cuando un virus invasor inyecta su propio código genético lleno de TCG y TCA e intenta decirle a la E. coli que produzca proteínas virales, estos ARNt alteran las instrucciones del virus. La inserción de los aminoácidos incorrectos da como resultado proteínas virales mal plegadas y no funcionales. Eso significa que el virus no puede replicarse y seguir infectando más células. No obstante, los virus también vienen equipados con sus propios ARNt. Estos aún pueden convertir con precisión TCG y TCA en serina. Pero Nyerges y sus colegas proporcionaron evidencia de que los ARNt engañosos que introdujeron son tan buenos en su trabajo que dominan a sus contrapartes virales.
Dicho de una forma sencilla, los expertos eliminaron secciones importantes en el virus que trabajaron para evitar el “crecimiento” del germen, además de insertarle “cordones tramposos”. De este modo, lo que hicieron fue “cortar” y desarrollar estas secciones para que, aunque un virus nuevo busque “crecer”, el patógeno elija a estos “tramposos” y permanezca inalterable. “Fue un gran desafío y un logro importante demostrar que es posible intercambiar el código genético de un organismo y que solo funciona si lo hacemos de esta manera”, afirmó Nyerges.
Este trabajo puede haber superado el último obstáculo al hacer que una bacteria sea inmune a todos los virus, aunque, según advirtieron los autores en su documento, “todavía existe la posibilidad de que aparezca algo que pueda romper la protección”. El equipo aseguró que superar los codones intercambiados requeriría que un virus desarrolle docenas de mutaciones específicas al mismo tiempo. “Eso es muy, muy poco probable para la evolución natural”, sugirió Nyerges.
La celda adecuada
Mantener a esta bacteria de diseño en un ámbito restringido ha implicado incorporar dos salvaguardas separadas. La primera protege contra la transferencia horizontal de genes, un fenómeno que ocurre constantemente en el que fragmentos de código genético y los rasgos que los acompañan, como la resistencia a los antibióticos, se transfieren de un organismo a otro.
Nyerges y sus colegas programaron una especie de corto circuito al hacer sustituciones a lo largo de los genes en las células de E. coli modificadas para que todos los codones que requieren leucina fueran reemplazados por TCG o TCA, los codones que en un organismo no modificado requerirían serina. La bacteria todavía producía leucina correctamente en esos lugares debido a sus ARNt tramposos. Sin embargo, si otro organismo incorporara alguno de los fragmentos modificados en su propio genoma, los ARNt naturales del organismo interpretarían TCG y TCA como serina y terminarían como proteínas basura que no transmiten ninguna ventaja evolutiva. “La información genética será un embrollo”, sostuvo el experto.
De manera similar, el equipo demostró que si uno de los tRNA engañosos de E. coli se transfiere a otro organismo, su lectura errónea de los codones de serina como de leucina daña o mata la célula, evitando una mayor propagación. “Cualquier ARNt modificado que escape no llegará muy lejos porque es tóxico para los organismos naturales. Este trabajo representa la primera tecnología que evita la transferencia horizontal de genes de organismos modificados genéticamente a organismos naturales” explicó Nyerges.
Para el segundo mecanismo de seguridad, el equipo diseñó a las propias bacterias de tal modo que no pudieran vivir fuera de un entorno controlado. El equipo utilizó una tecnología existente para hacer que la E. coli dependa de un aminoácido creado en laboratorio que no existe en la naturaleza. Los trabajadores que cultivan estos patógenos para producir insulina, por ejemplo, las alimentarían con el aminoácido no natural. Pero si alguna bacteria escapara, perdería el acceso a ese aminoácido y moriría.
“Por lo tanto, ningún humano u otra criatura corre el riesgo de infectarse con ‘superbacterias’”, enfatizó Nyerges. Los investigadores esperan explorar la reprogramación de codones como una herramienta para persuadir a las bacterias a producir materiales sintéticos médicamente útiles que, de lo contrario, requerirían una química costosa. “Aún quedan otras puertas por abrir. ¿Quién sabe qué más? Acabamos de empezar a explorar”, concluyó Nyerges. De este trabajo también participaron Svenja Vinke, Regan Flynn, Siân V. Owen, Eleanor A. Rand, Bogdan Budnik, Eric Keen, Kamesh Narasimhan, Jorge A. Marchand, Maximilien Baas-Thomas, Min Liu, Kangming Chen, Anush Chiappino-Pepe, Fangxiang Hu, Michael Baym y George M. Church.